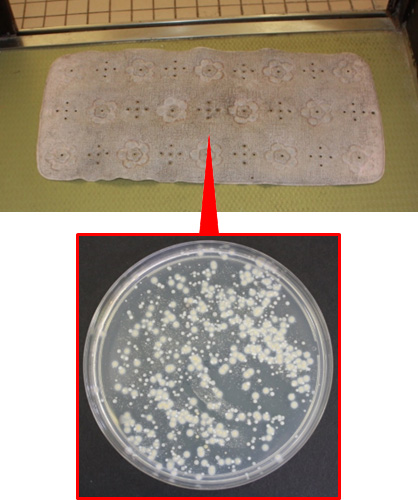

消毒NAVI
浴室

現場でお困りの消毒方法について、山陽小野田市立 山口東京理科大学 薬学部 教授 尾家 重治先生に解説していただきました。
なお、器具・物品や消毒剤等の取り扱いにつきましては、各製品の取扱説明書等をご確認ください。
浴室の消毒方法
(1)浴室内
洗浄剤を用いた洗浄で対応する。ただし、皮膚疾患(MRSA熱傷など)がある患者が使用後には、洗浄を兼ねた消毒が行える両性界面活性剤(アルキルジアミノエチルグリシン塩酸塩)の利用が望ましい。0.2%両性界面活性剤などで洗浄し、5分間以上放置してから洗い流す。この際に、両性界面活性剤の床面への適用では、床が滑りやすくなることに留意する。
(2)浴用椅子
浴用椅子は座面などがスポンジ様材質(ポリウレタンフォーム)でないものを使用する。スポンジ様材質の椅子は構造的に微生物汚染を受けやすいからである1)。消毒には両性界面活性剤などを用いる。
(3)浴用ストレッチャー
浴用ストレッチャーのマットも構造的に微生物汚染を受けやすい。使用のつどの洗浄と乾燥を行う(図1)。ただし、マットは構造的に洗浄や乾燥が十分に行えないので、術前・術後やコンプロマイズド・ホスト(易感染者)への使用では、使い捨てカバーを用いるのが望ましい(図2)。


(4)足拭きマット
脱衣所のバスマットの清潔保持には留意する必要がある。なぜなら、バスマットは微生物汚染を受けやすいからである。図3には、1か月間にわたるくり返し使用を行っていたバスマットの微生物汚染例を示した。また、バスマットはみず虫(白癬菌)の温床になり得ることも分っている2,3)。したがって、バスマットは洗濯が容易に行えるタオル地のものを用いて、すくなくとも1日1回などの頻回の洗濯が必要である。できれば、患者ごとに洗濯済みの足拭きタオルで対応する方法がもっとも望ましい。
1か月にわたるくり返し使用でMRSA(黄色コロニー)などの汚染を受けていた。
引用文献
- 1) Oie S, et al: Contamination of environmental surfaces byStaphylococcus aureusin a dermatological ward and its preventive measures. Biol Pharm Bull, 28: 120-123, 2005.
- 2) 丸山隆児,他:白癬の感染予防.真菌誌,44: 265-268, 2003.
- 3) 谷口裕子,他:足白癬患者からバスマットに散布された皮膚糸状菌の除菌方法の検討.日皮会誌,110: 1289-1293, 2000.【IC03611】